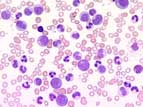

Kurzbeschreibung:
Die chronische myeloische Leukämie (CML) gehört zum Formenkreis der myeloproliferativen Neoplasien, ist charakterisiert durch eine leichte bis sehr starke Vermehrung reifer Granulozyten, myeloischer Vorstufen und Thrombozyten im peripheren Blut und ist auf molekularer Ebene definiert durch das Vorliegen eines BCR-ABL-Fusionsgens. Es handelt sich um eine Krankheit der pluripotenten Knochenmarksstammzelle. Das BCR-ABL-Fusionsgen kann in allen myeloischen Zelllinien und zu einem geringeren Anteil auch in Lymphozyten und Endothelzellen nachgewiesen werden. Der unbehandelte Verlauf ist geprägt durch eine unterschiedlich lange chronische Phase, die dann in eine Phase der Akzeleration übergeht undschliesslich in einer akuten Leukämie (Blastenschub) endet. In ca. 20-40% der Fälle wird die Diagnose beim asymptomatischen Patienten per Zufall gestellt.
Die atypische CML (aCML, BCR/ABL-negativ) wird gemäss der WHO 2008-Klassifikation den myelodysplastisch/myeloproliferativen Syndromen zugeordnet.
Klinisches Bild:
Symptome der CML sind Nachtschweiss, Gewichtsverlust, abdominelles Unbehagen durch die (fast obligate) Splenomegalie oder Müdigkeit im Rahmen einer Anämie. Die Inzidenz beträgt 1-2 Fälle pro 100'000 pro Jahr. Das mittlere Alter beträgt 50-60 Jahre. Die CML kommt in jedem Alter vor, ist bei Kindern und jungen Erwachsenen aber selten. Auslösende Faktoren sind nicht bekannt.
Pathogenese:
Die CML kommt durch eine balancierte Translokaltion zwischen den Chromosomen 9 und 22 zustanden. Dadurch entsteht das Fusionsgen BCR-ABL, welches das Fusionsprotein BCR-ABL kodiert. Im Gegensatz zur physiologischen, streng reguliert exprimierten Tyrosinkinase ABL, ist die aberrante BCR-ABL-Tyrosinkinase konstitutiv aktiv und induziert dadurch die ungehemmte myeloische Proliferation.
Therapie:
Bis im Jahr 2000 basierte die Therapie der CML auf Hydroxyurea und Interferon-alpha mit unbefriedigendem Ansprechen in der Mehrzahl der Patienten. Trotz Therapie entwickelten die Patienten nach durchschnittlich ca. 5 Jahren eine akzelerierte Phase und wenige Monate später eine Blastenkrise. Diese verlief fast immer rasch letal.
Mit Entwicklung des oralen Tyrosinkinase-Hemmers Imatinib (Glivec) hat sich die Behandlung der CML revolutioniert. Imitinib hemmt die konstitutiv aktive BCR-ABL-Kinase und blockiert damit die unkontrollierte Proliferation der CML-Zellen. Es handelt sich um das erste erfolgreiche Beispiel einer geziehlten Therapie ("targeted therapy"), die mit Hilfe eines kleinmolekularen Inhibitors den pathogenetischen Mechanismus einer Krankheit unterbricht. Mit Imatinib erreichen 97% der Patienten ein komplettes hämatologisches Ansprechen. Das 10-Jahresüberleben beträgt 84%. CML-assozierte Todesfälle sind heute selten. Neuere ABL-Hemmer wie Nilotionib (Tasigna), Dasatinib (Sprycel), Bosutinib (Bosulif) oder Ponatinib (Iclusig) sind noch potenter und wirken z.T. auch in Imatinib-resistenten Fällen. Die allogene Stammzelltransplantation hat heute nur noch bei Kindern und therapierefraktären Verläufen einen Stellenwert.
Hämatologie:
Bei der CML in chronischer Phase finden sich oft sehr hohe Leukozytenwerte bis 300 x109/L. Im peripheren Blut sind alle Entwicklungsstufen der Granulopoiese vom Promyelozyten bis zum segmentkernigen Granulozyten vertreten. Diese sind zytologisch unauffällig ohne Dysplasiezeichen. Blasten betragen in der chronischen Phase meist <2%. Eine Eosinophile ist typisch . Das Fehlen einer Basophilie macht die Diagnose einer CML unwahrscheinlich. Eine Thrombozytose ist häufig. Eine Anämie entwickelt sich meist erst bei steigenden Leukozytenzahlen.
Die akzelerierte Phase ist charakterisiert durch das Persistieren einer Leukozytose, Splenomegalie, Thrombozytose oder Thrombopenie trotz Therapie. Die Blasten können bis 20% ansteigen. Im Falle einer Blastenkrise können Blasten im peripheren Blut >20% betragen.
Knochenmark

In der chronischen Phase ist das Knochenmark hyperzellulär mit deutlicher Dominanz der Granulopoiese. Die verschiedenen Reifungsstufen vom Promyelozyten bis zum segmentkernigen Granulozyten liegen in normalem Verhältnis vor. Relevante Reifungsstörungen finden sich nicht. Die Blasten machen <5% aller Zellen aus. Die Megakaryozyten sind vermehrt und kleiner als normal, sogenannte Zwergenformen ("dwarf like megakaryocytes"). Typischerweise findet sich eine Eosinophilie und Basophilie. Pseudo-Gaucher-Zellen oder meerblaue Histiozyten ("sea blue histiocytes") sind typisch, kommen aber auch bei verschiedenen anderen Krankheiten vor. Eine Retikulinfibrose findet sich in 30% der Fälle.
In der akzelerierten Phase sind Blasten vermehrt, machen aber <20% der Zellen aus. Die Blastenkrise ist eine akute Leukämie auf dem Boden einer bekannten CML. Die Blasten betragen >20%. In 70% der Fälle sind sie myeloischer Natur, oft auch mit monozytärer, erythroider oder megakaryozytärer Ausreifung. In 30% handelt es sich um eine akute lymphoblastäre Leukämie.
Diagnose
Die Diagnose einer CML kann gemäss WHO 2008 bei gleichzeitigem Vorliegen eines BCR-ABL-Fusionsgens und einer reifzelligen, granulopoietischen Proliferation in Blut oder Knochenmark gestellt werden.
Ein BCR-ABL-Fusionsgen findet sich differentialdiagnostisch auch bei gewissen Fällen von akute B-lymphoblastischer Leukämie (B-ALL) und vereinzelt bei akuter myeloischer Leukämie (AML). In seltenen Fällen kann sich eine CML als isolierte Thrombozytose manifestieren, weshalb in solchen Fällen BCR-ABL immer mittels RT-PCR ausgeschlossen werden muss.
Bei Verdacht auf CML wird BCR-ABL mittels RT-PCR im Blut gesucht. Zudem gehört eine Knochenmarkuntersuchung inklusive Zytogenetik zur obligaten initialen Abklärung. Zytogenetisch kann in 90-95% der Fälle eine balancierte Translokation (9;22), das sogenannte Philadelphia-Chromosom (Ph), nachgewiesen werden. Zusätzliche zytogenetische Veränderungen liefern wichtige prognostische Informationen.